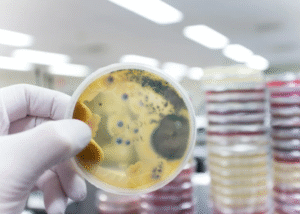
FunGuy Mold Inspections | Why We Treat Asbestos Inspections Like a “Time-Travel Mission” at Fun Guy Inspections FunGuy Mold Inspections | Why We Treat Asbestos Inspections Like a “Time-Travel Mission” at Fun Guy Inspections

Why We Treat Asbestos Inspections Like a “Time-Travel Mission” at Fun Guy Inspections
Most people think asbestos inspections are about clipboards, masks, and lab samples. At Fun Guy Inspections, we see them a little differently. To us, every property is a living archive, and every inspection feels like a guided trip through decades of construction habits, forgotten renovations, and hidden risks that only reveal themselves when you know where to look.
In other words, we don’t just inspect. We time-travel with purpose.
Understanding Buildings as Storytellers
Every structure speaks. It may not use words, but its materials, layers, and small inconsistencies whisper clues about the eras it has survived. Our team studies these clues with the same intensity that historians give to old manuscripts.
Many homes and commercial spaces still hold on to components that were installed long before asbestos became a known hazard. Some of these materials are clearly visible. Many are not. Our job is to read the “story” your building is trying to tell, so we can find risks long before they find you.
Why the Past Matters More Than Ever
Modern renovations often cover old problems instead of removing them. Drywall over tile. Flooring over flooring. Paint over joint compound. These layers act like pages binding together chapters from different decades.
When we walk into a structure, we’re not just looking at it as it stands today. We’re reading every chapter your building has lived through. This is why our approach is so different. We’re not scanning for asbestos randomly. We’re tracing its potential timeline.
Was the building constructed during a period when acoustical ceilings relied on asbestos fibers for texture
Did the property undergo a renovation when insulation products were still permitted to contain asbestos
Was the roofing installed before certain safety restrictions began
These questions guide the journey.
Our “Temporal Mapping” Approach
One of the most unique parts of our process is what we call temporal mapping. Instead of reviewing your property only by materials or rooms, we map it by the era in which each feature was likely built or rebuilt.
This lets us uncover risks that normal checklists would miss entirely. For example:
1. Materials that Don’t Match Their Era
A 1995 remodel using materials from leftover 1970s stock
A patched ceiling where only half the texture was replaced
A vintage HVAC component hidden behind a newer grille
When the timeline doesn’t match, we investigate.
2. “Renovation Layer Conflicts”
This occurs when a quick renovation created a new layer over an older, hazardous one. Many contractors had no idea asbestos might be present, so they simply covered the old surface. We specialize in identifying these conflicts.
3. Forgotten Rooms
Attics, utility closets, crawlspaces, above-ceiling voids. These tucked-away areas are often untouched for decades. We treat them as museums.
Why Our Time-Travel Style Works
Our method is not about being poetic. It is about being precise.
Asbestos risks rarely announce themselves. They hide in corners, behind walls, inside insulation, or inside perfectly clean-looking ceilings. By understanding the construction history of each space, we can:
- Spot hidden asbestos-containing material
- Prevent unsafe DIY renovation surprises
- Reduce demolition delays
- Protect families and teams
- Provide results that help your next steps
This time-aware strategy helps us protect both people and property with a special level of accuracy.
Our Commitment to Protecting Your Future
Fun Guy Inspections is built on the belief that every building deserves a full story reveal before anyone drills, sands, removes, or demolishes anything. We guide you chapter by chapter through the findings so you can understand where risks came from and how best to handle them.
You get a clearer picture, better planning options, and the peace of mind that comes from knowing your building’s past will not harm its future.
Asbestos inspections shape healthier remodels and safer living environments, but they also help uncover the hidden journeys your building has taken over time. When we show up, we are part historian, part detective, part protector. Our goal is to give you clarity through a process that most people find confusing.
If you’re planning construction, renovations, or simply want to know what your space is hiding, our team is ready. With every inspection, we help you step confidently into the future by understanding the past.